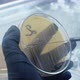
Biomass Harvest - VideoHive Item for Sale

A collection of videos on biology and microbiology. Video with Petri dishes and bacteria, experiments, tests, microscopy.
-
13 Sales $9
-
1 Sale $36
-
15 Sales $39
-
0 Sales $14
-
1 Sale $13
-
0 Sales $15
-
1 Sale $33
-
0 Sales $17
-
0 Sales $13
-
0 Sales $13
-
1 Sale $18
-
0 Sales $13